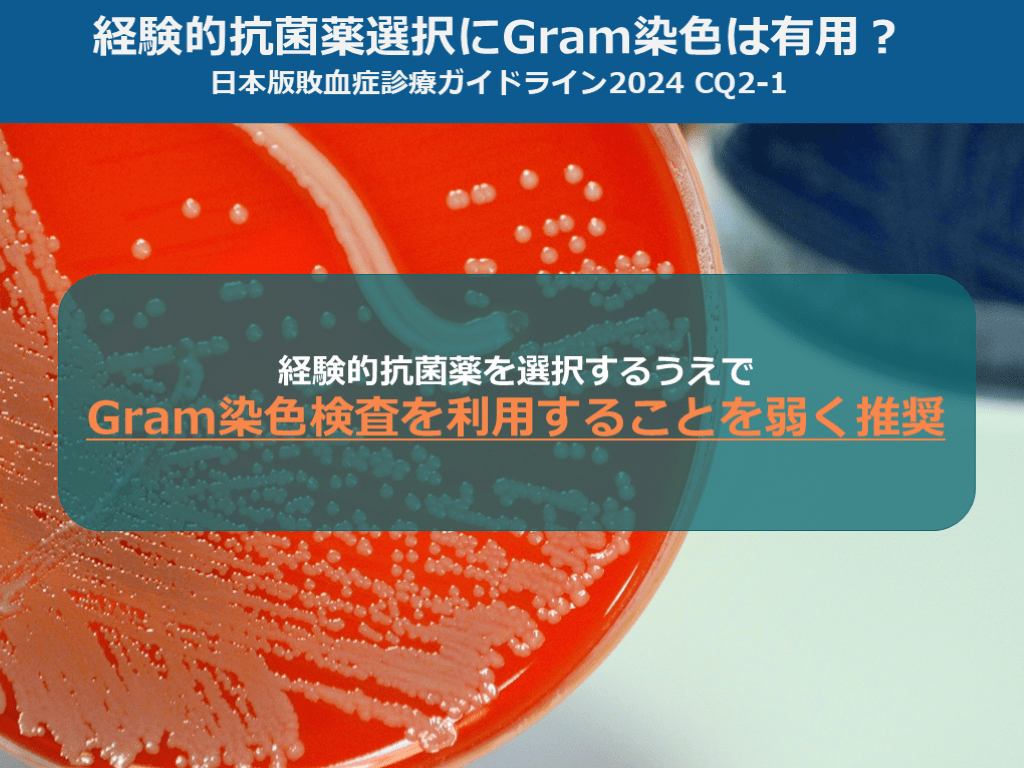
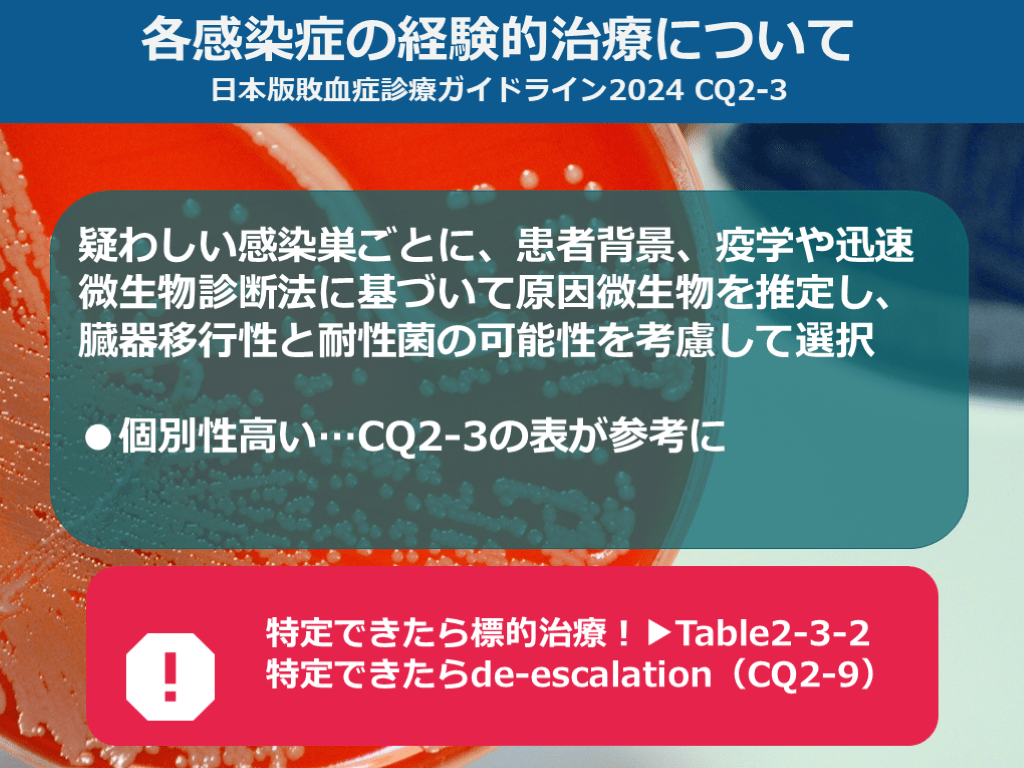
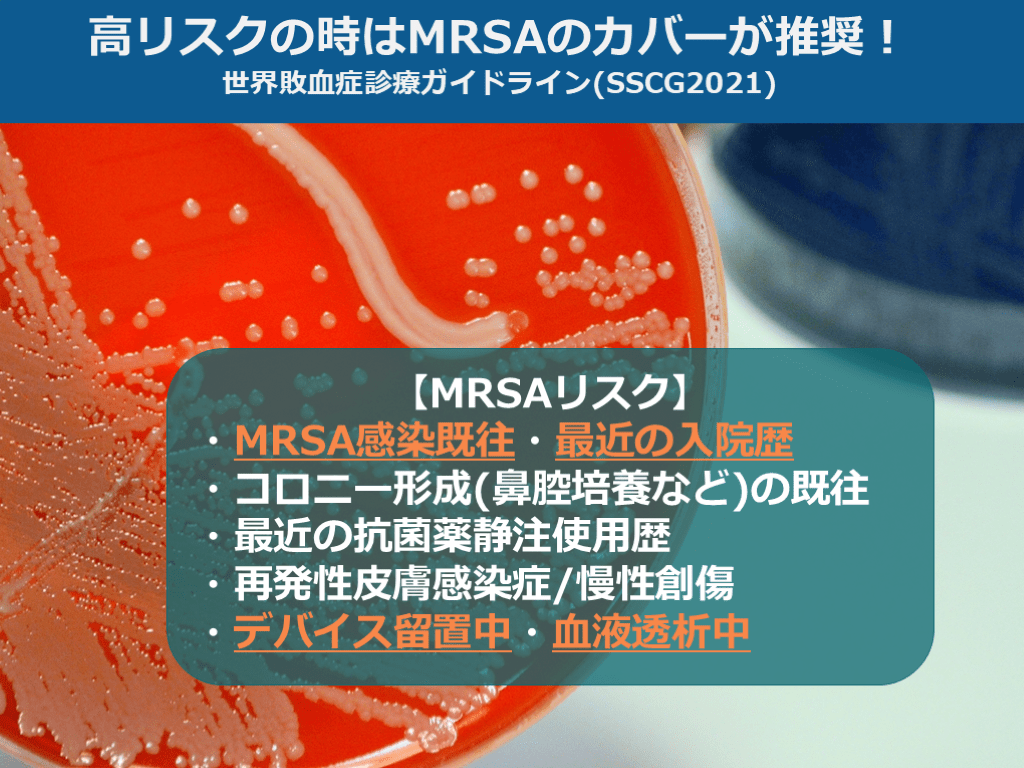

関連するスライド
救急のABCを問い直す ― “なんとなく”から抜け出せ!
芥川晃也
29709
74
「鑑別力」を進化する ER思考
かんぱち
26291
148
クリスマスにはトナカイ咬傷が増えるのでは?
住吉翔元
14994
19
回復期病棟におけるCOVID-19感染対策(2020年9月版)
黒田浩一
574987
94
【J-SSCG2024準拠】敗血症診療のまとめ
三谷雄己
Award 2023 受賞者
広島大学病院
5,043,945
4,847
概要
世界敗血症診療ガイドライン(SSCG2021)・日本版敗血症治療ガイドライン2024を参照し、敗血症の定義の変遷・生理学・治療と管理を中心にまとめました。
NEJMより敗血症治療に関する論文が相次いで出ましたので、周辺分野に関して大幅にアップデートしました(2024年11月)
研修医や専攻医などの若手医療従事者の方々の学習や、普段敗血症を診療される先生方の復習にご利用いただければ幸いです。
本スライドの対象者
研修医/専攻医
投稿された先生へ質問や勉強になったポイントをコメントしてみましょう!
0 件のコメント
三谷雄己さんの他の投稿スライド
【10分で学ぶ】発熱≠感染症【まず考えるべき非感染性発熱】
三谷雄己
6,744
39
冬場に多い入浴中のヒートショック サウナをきっかけに学ぼう
三谷雄己
20,274
29
Primary survey 呼吸(B)の異常【メカニズムの評価を中心に】
三谷雄己
146,289
318
このスライドと同じ診療科のスライド
テキスト全文
敗血症の定義と診断基準の概要
#1.
-
#2.
敗血症 Sepsis
#3.
世界では 3秒に1人が 敗血症で命を落とす 世界敗血症同盟(GSA:Global Sepsis Alliance)
#4.
敗血症での死亡 ●毎年3100万人が罹患 特に高所得国での罹患率が上昇 Crit Care 2015; 19:21 ●死亡率 敗血症 25-30% 敗血症性ショック 40-50% Lancet Respir Med 2014; 2
#5.
目次 ①ER編 1.敗血症の定義と診断 2.敗血症の治療総論 3.敗血症治療のピットフォール ②ICU編 1.ショックの認識と生理学 2.治療の各論 ③敗血症×α おまけ編
Sepsis-1からSepsis-3までの進化
#6.
①ER編 1.敗血症の定義と診断 2.敗血症の治療総論 3.敗血症治療のピットフォール ②ICU編 1.ショックの認識と生理学 2.治療の各論 ③敗血症×α おまけ編 目次
#7.
敗血症の定義 ●敗血症≒菌血症の時代を経て 定義は改訂されてきた 1991年 Sepsis-1 2001年 Sepsis-2 2016年 Sepsis-3 202年 Sepsis-3を踏襲(New!)
#8.
Sepsis-1 ●1991年 米国の専門家達により提案 「感染による全身性炎症反応症候群 (SIRS)」 ※SIRS:上記状態のうち2つ以上を満たした場合 感染症が疑われ、SIRSの基準を満たすもの=敗血症 その中で臓器障害を伴うもの=重症敗血症
#9.
Sepsis-1に対する疑問や問題点 ●簡便で広く定着したが… ●SIRSは敗血症に対して感度は高い 一方で特異度が低い… ●入院患者の約半数は入院中一度は SIRSの2項目陽性に Am J Respir Crit Care Med. 2015 ;192(8)
#10.
SIRS基準は敗血症患者の8人に1人を見逃している NEJM 2015 March 17 online first
#11.
Sepsis-2 ●2001年 欧州・米国の専門家達より提言 「感染に起因する全身症状を伴った症候群」 【診断基準】 ●24項目のチェックリスト ※項目数規定なし 【診断】 ・敗血症 ・重症敗血症 ・敗血症性ショック の3種類
#12.
Sepsis-2に対する疑問や問題点 ●とにかくめんどくさい… ・何項目以上で診断というカットオフが存在しない ・そのうえ診断精度も大して向上しなかった →簡便で客観的なSepsis-1が使われ続けた
#13.
Sepsis-3 「感染に対する生体反応が調節不能な状態となり, 重篤な臓器障害が引き起こされる状態」 引用)日本版敗血症診療ガイドライン 2024 【診断基準】 感染症もしくは 感染症の疑いあり + SOFAスコア 2点以上の急上昇
#14.
Sepsis-3 「感染に対する生体反応が調節不能な状態となり, 重篤な臓器障害が引き起こされる状態」 引用)日本版敗血症診療ガイドライン 2024 【診断基準】 感染症もしくは 感染症の疑いあり + SOFAスコア 2点以上の急上昇 日本版敗血症診療ガイドライン2024でも 敗血症の定義はSepsis-3を踏襲している
quick SOFAの重要性と使用法
#15.
Sepsis-3に対する疑問や問題点 ●やっぱりめんどくさい… ●一般病棟やERで早期発見する方法ってない…? ☞quick SOFAが提唱された
#16.
quick SOFA 日本版敗血症診療ガイドライン2020 ●意識状態の変化 ●RR 22 /min 以上 ●sBP 100 mmHg以下 2つ満たせば敗血症疑い
#17.
敗血症○✕クイズ q-SOFA<2なら感染症ではない?
#18.
-
#19.
●意識状態の変化 ●RR 22 /min 以上 ●sBP 100 mmHg以下 2つ満たせば敗血症疑い quick SOFA 日本版敗血症診療ガイドライン2020 診断基準ではない あくまでスクリーニング
#20.
quick SOFA単独使用の推奨度↓ 世界敗血症診療ガイドライン(SSCG2021) 敗血症/敗血症性ショックのScreening qSOFAを単独で使用しないことを推奨 (Strong recommendation, moderate-quality evidence) ※ SIRS, NEWS, MEWSなどと比較
#21.
日本版敗血症診療ガイドライン 2024 におけるquickSOFAの記載 qSOFAは感度が低い可能性が指摘されており SIRSやNEWSといったスコアを含めた知見を 整理することは臨床において有用である
#22.
ERにおけるquick SOFA 敗血症診断の感度は32%との報告も Scand J Trauma Resusc Emerg Med. 2017;25:56 SOFAはそもそも臓器障害を評価するツール quick SOFAは臓器障害をスクリーニング quick SOFAの立ち位置を再確認 感染症かどうかを判断するツールではない!
感染症を疑う際の問診ポイント
#23.
敗血症診断の流れ 日本版敗血症診療ガイドライン2020
#24.
いつ感染を疑う? 発熱? CRP上昇? 感染を早期に疑うのが大切!でも…
#25.
38.3℃以上 ※根拠なし Guidelines for evaluation of new fever in critically ill adult patients: 2008 update from the American College of Critical Care Medicine and the Infectious Diseases Society of America 37.8℃以上(単回) 37.2℃以上(複数回) 1.1℃以上↑(ベースラインから) ※口腔温 Clinical practice guideline for the evaluation of fever and infection in older adult residents of long-term care facilities 発熱の定義は様々…
#26.
38.3℃以上 ※根拠なし Guidelines for evaluation of new fever in critically ill adult patients: 2008 update from the American College of Critical Care Medicine and the Infectious Diseases Society of America 37.8℃以上(単回) 37.2℃以上(複数回) 1.1℃以上↑(ベースラインから) ※口腔温 Clinical practice guideline for the evaluation of fever and infection in older adult residents of long-term care facilities 高齢者の1/3は発熱が目立たない Emerg Med Clin North Am. 2016 34(3)
#27.
高齢者の感染症は発熱がないことが多い 「老いた、ボケたは感染症!」 お:嘔吐 感染症では化学受容体が刺激される い:息切れ q-SOFAの頻呼吸に注目 た:立てない、倒れやすい、だるい 全身倦怠感は重要なサイン ボケた:意識変容 中枢性疾患や低血糖、慢性硬膜下血腫との鑑別 引用)Dr.林の高齢者救急・急変お助け本 ─高齢者が好きになる 臓器非特異的な症状の急性経過(数時間~数日) ➡発熱がなくても感染症を鑑別に(低体温も) 引用)レジデントノート 羊土社 Vol.23 No.13 2021
#28.
CRPやPCTって診断に有用じゃないの…? 日本版敗血症診療ガイドライン2024 CQ1-6 CRP、PCT、P^SEP、IL-6は単独で高い診断精度は示されていない… バイオマーカー単独による敗血症診断は一般的に困難
#29.
高齢者の感染症を見抜くには… 悪寒戦慄と経口摂取量も大事 菌血症の可能性 悪寒戦慄の存在>40℃以上の発熱 経口摂取が8割以上あれば否定的 J Hosp Med. 2017:12
#30.
感染症を疑う際の問診ポイント ①前医での抗生剤投与・処方の有無 ②直近の入院歴 ③敗血症での入院歴 再度罹患しやすく死亡率も高い(免疫抑制状態の遷延…) 【再入院のリスク】 ・長期間の抗生剤投与 ・経静脈栄養・退院時の貧血 Crit Care Med.2016;20:93 ④増悪因子(DM,LC,HT,ステロイド,癌) ⑤流行の感染症(ワクチン接種歴含む)
敗血症診断の流れと初期治療
#31.
感染源の検索 Commonな部位 機能/構造異常のある部位
#32.
日本のICU入院 敗血症患者の内訳 引用) Crit Care ,22: 322,2018 画像引用)レジデントノート 羊土社 Vol.23 No.13 2021 肺炎・腹腔内感染症 尿路感染症・軟部組織感染症で9割を占める
#33.
機能/構造異常をチェック ●あるはずのものがない ・嚥下機能・排尿機能・⽪膚バリア ・脾臓摘出後 ●ないはずのものがある ・結⽯・腫瘍・創傷 ・カテーテル等の⼈⼯物
#34.
決め打ちしすぎない Top to bottom アプローチで診察を
#35.
参考 Top to bottomアプローチの例 画像引用)レジデントノート 羊土社 Vol.23 No.13 2021
#36.
身体診察のPit Fall ●見えないカバーされている部分 ●ドレッシングされている創部やカテ ●パルスオキシメーターで隠れている指 (感染性心内膜炎) ●痰やドレーンの廃液を見ない ●時間節約のためにシステマティックな身体診察を行わない ●圧がかかる部位 (後頭部、踵、仙骨部仙骨部、臀部)を見ない ●眼底検査や直腸骨盤診察をしない (患者の尊厳に常に配慮しながら)
#37.
感染源検索と画像検査 日本版敗血症診療ガイドライン2024 CQ1-7 ●画像検査の第一選択はエコー検査が多い ●経胸壁に比べ経食道エコーの方がIEの診断制度↑ ●壊死性軟部感染症は外科的切開が最重要!
#38.
まとめ 感染と臓器障害を疑ったら 日本版敗血症診療ガイドライン 2024 迅速評価と初期治療バンドル(後述)を行う
敗血症性ショックのメカニズムと治療
#39.
目次 ①ER編 1.敗血症の定義と診断基準 2.敗血症の治療総論 3.敗血症治療のピットフォール ②ICU編 1.ショックの認識と生理学 2.治療の各論 ③敗血症×α おまけ編
#40.
敗血症は 内科的エマージェンシー なぜ治療を急ぐのか
#41.
初回抗菌薬投与が1時間遅れる毎に 死亡率が増加(平均7.6%) Crip Care Med. 2006 ;34(6) 適切な抗菌薬投与と死亡率 適切な抗菌薬投与まで 時間と死亡のリスク
#42.
初期治療バンドル 日本版敗血症診療ガイドライン 2024 敗血症を疑った際には,直ちに開始
#43.
敗血症性ショックのメカニズムは複合的 画像引用)レジデントノート 羊土社 Vol.23 No.13 2021 心原性 血液分布異常性 循環血液量減少性
#44.
敗血症性ショック まずは輸液負荷 画像引用)レジデントノート 羊土社 Vol.23 No.13 2021 心原性 血液分布異常性 循環血液量減少性 輸液負荷
#45.
初期輸液速度と輸液量 日本版敗血症診療ガイドライン2024 CQ3-5 ●循環血漿量の適正化を目標 ●晶質液30ml/kg以上を3時間以内 ●Lac値・輸液反応性を見ながら いつからをNAdを併用するか明確な根拠はないが… 過剰輸液の害を考慮しつつ遅延なく!
#46.
好気性・嫌気性代謝の生化学 嫌気性代謝=Lac↑ Lac↑は酸素需要供給バランスの破綻を示唆する可能性 スライド画像)広島大学病院 演者作成
抗生剤投与のタイミングと選択
#47.
循環の指標としての乳酸値 ●乳酸値をモニターしたほうが院内死亡率が低い Am J Respir Crit Care Med 2010;182 外科的(ST) 経皮的(PT) 乳酸値が下がらない ≒ショックの遷延
#48.
乳酸値モニタリングについて 世界敗血症診療ガイドライン(SSCG2021) ●成人敗血症ではLacをモニタリング (Weak recommendation, low-quality evidence) Lacは敗血症の最終診断に関与 ●Lac高値 を下げるように治療介入 (Weak recommendation, low-quality evidence)
#49.
敗血症における血液培養 日本版敗血症診療ガイドライン2024 CQ1-4 ●抗生剤投与前に2セット以上提出 1セットあたり20-30mlを採取 血液培養の陽性率:5-13% コンタミ率:20-56% ●セットの数を増やせば感度は上昇 1セット:約80% 2セット:約89% 3セット:約98%との報告あり ●基本は2セット提出(IEのみ3セット) 引用:日本版敗血症診療ガイドライン2020
#50.
感染が疑われる部位から培養検体を採取 ●喀痰培養(肺炎の補助診断に) 吸引痰:菌数は105CFU/ml以上で感度76%・特異度68% 肺炎によるARDS・患者の免疫力低下している時BAL検体提出検討 ●尿培養(UTIの補助診断に) 再発性や難治性の場合は抗菌薬を2-3日休薬して提出を検討 ●髄液培養(髄膜炎の補助診断に) 時間がかかる場合は抗菌薬投与優先 抗菌薬投与前の陽性率70-80% 投与後50%以下 敗血症における各種培養検体について 日本版敗血症診療ガイドライン2024 CQ1-5
#51.
抗生剤加療は1時間以内…? 日本版敗血症診療ガイドライン2024 CQ2- 2 敗血症・敗血症性ショックと認識した後 抗菌薬は可及的早期に開始するが 必ずしも1時間以内という目標を 用いないことを弱く推奨する ●全死亡に関する効果推定値は低い ●薬剤が不要な患者に十分な評価がなされる前に 投与が行われる可能性がある
#52.
急いで抗生剤加療をするのが強調 一方、世界では… 世界敗血症診療ガイドライン(SSCG2021)
#53.
極論ですが…ERでの抗生剤投与は これだけは押さえておく!! 引用:内科救急のロジック
#54.
経験的抗菌薬の選択 日本版敗血症診療ガイドライン2024 CQ2-3 疑わしい感染巣ごとに患者背景や各種検査所見での 原因微生物の推定臓器移行性と耐性菌の可能性を 考慮し選択する ▶J-SSCG2024のスマホアプリが有用
輸液管理と血圧維持の重要性
#55.
経験的抗菌薬選択にGram染色は有用? 日本版敗血症診療ガイドライン2024 CQ2-1 経験的抗菌薬を選択するうえで Gram染色検査を利用することを弱く推奨
#56.
各感染症の経験的治療について 日本版敗血症診療ガイドライン2024 CQ2-3 疑わしい感染巣ごとに、患者背景、疫学や迅速微生物診断法に基づいて原因微生物を推定し、臓器移行性と耐性菌の可能性を考慮して選択 ●個別性高い…CQ2-3の表が参考に 特定できたら標的治療!▶Table2-3-2 特定できたらde-escalation(CQ2-9)
#57.
経験的治療+αの加療 日本版敗血症診療ガイドライン2024 CQ2-4,5 ●カルバペネム系抗菌薬 ESBL産生菌・耐性緑膿菌 /アシネトバクターが推定されるとき ●抗MRSA抗菌薬 保菌リスク(DM・透析・COPD・心不全などの医療暴露) 感染巣、患者背景などで考慮
#58.
高リスクの時はMRSAのカバーが推奨! 世界敗血症診療ガイドライン(SSCG2021) 【MRSAリスク】 ・MRSA感染既往・最近の入院歴 ・コロニー形成(鼻腔培養など)の既往 ・最近の抗菌薬静注使用歴 ・再発性皮膚感染症/慢性創傷 ・デバイス留置中・血液透析中
#59.
βラクタム系は持続投与…? 日本版敗血症診療ガイドライン2024 CQ2-7 持続投与もしくは投与時間の延長 を弱く推奨 ●17つのRCTのメタ解析で死亡率減少 ●初回ボーラス投与後維持投与が SSCG2021でも推奨
#60.
グリコペプチド系は持続投与…? 日本版敗血症診療ガイドライン2024 CQ2-7 持続投与もしくは投与時間の延長 を行わないことを弱く推奨 ●PK/PDの観点からは有用…?しかし ●3つのRCTのメタ解析で死亡率増加 副作用は減少
#61.
TDMを活用した用量調整は…? 日本版敗血症診療ガイドライン2024 CQ2-7 活用を弱く推奨 ●Therapeutic Drug Monitoring (治療薬モニタリング)の略 ●血中薬物濃度を測定し、そのデータを基に 薬剤の投与量を適正化 ●薬物の有効性を最大化し、副作用を最小限に 抑えるのが目的
#62.
敗血症○✕クイズ 1時間バンドルを達成すればOK?
ショックの診断基準と治療介入
#63.
-
#64.
敗血症バンドルの図解 引用:Medicina Vol.58 No.4 2021増刊号
#65.
敗血症バンドルの図解 引用:Medicina Vol.58 No.4 2021増刊号 この中にソースコントロールは 含まれていない!
#66.
感染源を同定後、可能な限り速やかにソースコントロールを実施 日本版敗血症診療ガイドライン2024 CQ1-8 外科的(ST) 経皮的(PT) デバイス感染ならデバイスを抜く 膿瘍ができてるならドレナージする 創部感染なら洗浄する ※感染性膵壊死は待機的介入が◎ CQ1-8参照 ●流れが詰まる・よどむ 閉塞性腎盂腎炎・閉塞性化膿性胆管炎/胆嚢炎 ●菌の供給源がある カテーテル感染症・感染性⼼内膜炎・消化管穿孔 ●血流がない(壊死や膿瘍) 壊死性筋膜炎・深頸部膿瘍・膿胸・肺膿瘍
#67.
目次 ①ER編 1.敗血症の定義と診断基準 2.敗血症の診断・治療総論 3.敗血症治療のピットフォール ②ICU編 1.ショックの治療総論 2.治療の各論 ③敗血症×α おまけ編
#68.
いつ ショックと 認識するのか?
#69.
敗血症性ショックの診断基準 日本版敗血症診療ガイドライン2024 敗血症の診断基準を満たしたうえで 「十分な輸液負荷にもかかわらず、 平均血圧を65mmHg以上に保つ ために循環作動薬を必要とし、 かつ血中乳酸値が2mmol/Lを 超えるもの」 …???
#70.
ショック≠血圧低値 バイタルサインのみでショックを判断しない スライド画像)広島大学病院 演者作成
敗血症における循環指標の評価
#71.
ショックは3つの窓で見抜く! スライド画像)広島大学病院 演者作成
#72.
循環の指標としてのCRTは有用 日本版敗血症診療ガイドライン2024 CQ3-1 ●CRT(capillary refilling time) ⇒毛細血管際充満時間 ●乳酸値よりも早期の指標として有用! ●CRT延長は小児では脱水や重症感染症の予測に有用 ●ICU入室患者群で血圧安定後のCRT延長(4.5秒以上)は 臓器障害のリスクとなる Packard A ,et al Capillary refill time :Is it still useful clinical sign? Anesth Analg, 113 :120-123 ,2011 Lima A ,et al :The prognostic value of the subjective assessment of peripheral perfusion in critically ill patients. Crit Care Med, 37:934-938, 2009
#73.
敗血症とCRTについて 年齢・体温・気温の影響を受けるため、 再現性が低いことを忘れずに… ●敗血症性ショックでの初期蘇生終了後6時間後の CRT延長は14日後の死亡率の強い予測因子となる ●敗血症性ショックにおける蘇生中の正常化までの時間は CRTで2時間 / 乳酸値で6時間である Ait-Oufella H, et al : Capillary refill time exploration during septic shock. Intensive Care Med, 40:958-964, 2014 Hernandez G, et al : Evolution of peripheral vs metabolic perfusion parameters during septic shock resuscitation. A clinical-physiologic study. J Crit Care, 27: 283-288, 2012
#74.
循環の指標としてのmottling(網状皮斑) ●mottling(網状皮斑)は敗血症や重症患者にみられ 膝や肘から始まり時に耳や指にも広がる 外科的(ST) 経皮的(PT) レジデントノート vol.20 No8 (増刊) 2018年 Ait-Oufella H ,et al :Motting score predicts survival in septic shock. Intensive Care Med, 37 :801-807, 2011
#75.
【ショックの治療介入】 ①臓器灌流を維持(MAP 65mmHg以上) ②酸素供給量を増やす ③酸素需要量を減らす ショックとは酸素需給バランスの破綻 スライド画像)広島大学病院 演者作成
#76.
【ショックの治療介入】 ①臓器灌流を維持(MAP 65mmHg以上) ②酸素供給量を増やす ③酸素需要量を減らす まずは血圧を維持 スライド画像)広島大学病院 演者作成
#77.
血圧がなければ末梢へ酸素を届けられない 臓器灌流を規定する血圧=MAP(平均動脈圧) 臓器灌流 意識してますか…? スライド画像)広島大学病院 演者作成
#78.
平均血圧 心拍出量 血管抵抗 1回心拍出量×心拍数 (前負荷・心収縮力・後負荷) まずは平均血圧(MAP)を維持 スライド画像)広島大学病院 演者作成
輸液負荷と昇圧薬の使用法
#79.
心拍出量↑ 血管抵抗 1回心拍出量↑×心拍数 (前負荷↑・心収縮力・後負荷) 輸液の目的は平均血圧の維持 輸液負荷 スライド画像)広島大学病院 演者作成
#80.
敗血症性ショック まずは輸液負荷 画像引用)高場章宏 編 レジデントノート 羊土社 Vol.23 No.13 2021 心原性 血液分布異常性 循環血液量減少性 輸液負荷
#81.
初期輸液速度と輸液量 日本版敗血症診療ガイドライン2024 CQ3-5 ●循環血漿量の適正化を目標 ●晶質液30ml/kg以上を3時間以内 ●Lac値・輸液反応性を見ながら
#82.
初期輸液蘇生に不応の敗血症はどこで管理? 日本版敗血症診療ガイドライン2024 CQ1-9 集中治療が行える場所で管理する!
#83.
輸液 世界敗血症診療ガイドライン(SSCG2021) MAP65mmHg以上 動的指標を用いて(SSCG2021) Bentzer P ,et al :Will This Hemodynamically Unstable Patient Respond a Bolus of Intravenous Fluids? JAMA, 316 :1298-1309, 2016
#84.
輸液 輸液反応性と診断特性に注目 PLR(半座位⇒頭部フラット+下肢45°挙上)が有用 自己輸血(約300ml)に相当 CO上昇=輸液反応性あり
#85.
十分な輸液負荷は大切だが… 大量輸液負荷 に伴う 静水圧性肺水腫
#86.
敗血症に対する昇圧薬 日本版敗血症診療ガイドライン2024 CQ3-7 第一選択:ノルアドレナリン 第二選択:バゾプレシン ドパミン? ノルアドレナリンのほうが28日死亡率を有意に 改善させ、合併症(特に不整脈)を減少させた。
敗血症に対する治療戦略のまとめ
#87.
初期輸液速度と輸液量 日本版敗血症診療ガイドライン2024 CQ3-5 ●循環血漿量の適正化を目標 ●晶質液30ml/kg以上を3時間以内 ●Lac値・輸液反応性を見ながら いつからをNAdを併用するか明確な根拠はないが… 輸液負荷の害を考慮しつつ遅延なく!
#88.
輸液負荷に加え血管収縮薬の併用! 画像引用)高場章宏 編 レジデントノート 羊土社 Vol.23 No.13 2021 心原性 血液分布異常性 循環血液量減少性 輸液負荷 血管収縮薬
#89.
ノルアドレナリンは末梢静脈路から早期投与OK 日本版敗血症診療ガイドライン2024 CQ3-6 ●末梢からのカテコラミン投与 比較的安全 0.1-0.2γ程度までで1-2日であれば許容 Ballieu P, et al: J Intensive Care Med; 36: 101, 2021 ●なるべく肘窩の近くの肘静脈など 大きな末梢静脈からの投与を Evans Laura, et al: Critical Care Medicine: Vol.49 Issue 11 1063-143, 2021
#90.
具体的なアクションプランの一例 画像引用)三谷雄己, みんなの救命救急科 中外医学社出版
#91.
参考:初期蘇生にEGDTを用いるか…? 日本版敗血症診療ガイドライン2020 CQ6-2 ※2024は記載なし 図引用:田中竜馬著 「敗血症の初期蘇生においてEGDTプロトコールは有効か?」 医学書院 https://www.igaku-shoin.co.jp/paper/archive/y2014/PA03102_02 経皮的(PT) 敗血症性ショック患者で、初期蘇生として EGDTを行わないことを弱く推奨する ●バンドルの遵守率が死亡率の 低下と相関(5人/1000人) ⇒限定的… ●SGC留置・CVP測定が必須… ●生理学的パラメータを正常化 ≠生存率を上げる
#92.
目次 ①ER編 1.敗血症の定義と診断基準 2.敗血症の診断・治療総論 3.敗血症治療のピットフォール ②ICU編 1.ショックの認識と生理学 2.治療の各論 ③敗血症×α おまけ編
#93.
初期輸液速度と輸液量 日本版敗血症診療ガイドライン2024 CQ3-5 ●循環血漿量の適正化を目標 ●晶質液30ml/kg以上を3時間以内 ●Lac値・輸液反応性を見ながら
#94.
大量輸液負荷➡うっ血性肺水腫 輸液負荷をすベきとはいうものの… スライド画像)広島大学病院 演者作成 ICU敗血症性ショック患者(1L負荷後) 輸液制限(中央値1798ml)vs標準輸液(中央値3811ml) 大きな転機に差なし (※secondary outcome 標準輸液群で腎障害/虚血合併症が多い傾向) ➡輸液制限で死亡率は増加しない Meyhoff TS, et al. N Engl J Med. 2022 30;386
輸液反応性の評価と管理
#95.
心拍出量 1回心拍出量 ×心拍数 心拍出量を増やすには…? 前負荷・心収縮力・後負荷 輸液負荷 強心薬 輸液反応性をチェック スライド画像)広島大学病院 演者作成
#96.
MAP65mmHg以上 上限の規定なし(SSCG2016) Bentzer P ,et al :Will This Hemodynamically Unstable Patient Respond a Bolus of Intravenous Fluids? JAMA, 316 :1298-1309, 2016 輸液するかどうか 輸液反応性を参考に
#97.
ICUでの輸液戦略 SVV・PPVとは? MAP65mmHg以上 上限の規定なし(SSCG2016) 引用)ブラッシュアップ 敗血症
#98.
ICUでの輸液戦略 SVV・PPVとは? MAP65mmHg以上 上限の規定なし(SSCG2016) 引用)Michard F.Anesthesiology. 2005:103 419-28 , ブラッシュアップ 敗血症
#99.
引用)Bentzer P ,et al :JAMA, 316 :1298-1309, 2016 輸液するかどうか 輸液反応性を参考に
#100.
輸液反応性をPLRで見てみよう… 画像引用)高場章宏 編 レジデントノート 羊土社 Vol.23 No.13 2021 意外と難しい…
#101.
そもそも輸液反応性があれば輸液負荷すべき…? スライド画像)広島大学病院 演者作成
#102.
そもそも輸液反応性があれば輸液負荷すべき…? スライド画像)広島大学病院 演者作成
DIC診断と治療の原則
#103.
輸液反応性≠輸液負荷 真に輸液が必要かどうかは 循環不全の有無で判断! ①循環不全を疑う所見 ⇩ ②輸液反応性の評価 ⇩ ③輸液負荷 スライド画像)広島大学病院 演者作成
#104.
低用量ステロイド 世界敗血症診療ガイドライン(SSCG2021) Hydrocortisone 50mg×4回/日 or 200mg/日持続投与 ●ショックの離脱は早まるが、28日死亡率は改善しない ●ショックに陥ってから6時間以内の投与開始で 28日死亡率が改善するかもしれない ●ショックではない敗血症患者への投与では、 ショックの発生率や死亡率を改善しなかった Early initiation of low-dose corticosteroid therapy in the management of septic shock. Crit Care 2012:16:R3
#105.
敗血症患者のHRコントロールは…? 日本版敗血症診療ガイドライン2024 CQ3-10 ●初期蘇生輸液でコントロール困難な 頻脈に対して短時間作用型 β1受容体遮断薬の投与を弱く推奨 HR95以上の患者群に介入し、従来治療群に対し 死亡減少・ICU滞在日数減少を有位に認めた ※徐脈・徐脈性不整脈に注意
#106.
PCTを指標とした治療終了は…? 日本版敗血症診療ガイドライン2024 CQ2-11 敗血症に対する抗生剤治療において、PCTを指標とした治療終了を行う ことを弱く推奨する ●転機を悪化させることなく抗菌薬投与日数を 短縮できないかという視点からの臨床疑問 ●RCT16論文でのNMA 28日死亡率低下 抗菌薬投与日数短縮
#107.
注意!PCTによる抗生剤加療開始は…? 世界敗血症診療ガイドライン(SSCG2021) 抗菌薬開始の指標としてPCTを使用しない (Weak recommendation, very low quality of evidence) ※メタアナリシスで長期死亡率・再入院率・非入院日数有意差なし ※バイオマーカー単独による敗血症診断は一般的に困難 (J-SSCG2024)
#108.
免疫グロブリン静注(IVIG)について 日本版敗血症診療ガイドライン2024 CQ6-1 敗血症に対してIVIG投与を行わないことを弱く推奨 ※劇症型溶血性レンサ球菌感染症のような特殊病態に応じた 適応判断を否定するものではない
#109.
血糖管理 日本版敗血症診療ガイドライン2024 CQ6-3 目標:144-180mg/dL 2009年 NICE-SUGAR study (集中治療領域の血糖管理における最大規模のRCT) ●血糖値≦180mg/dLで病院死亡率・感染症発生率 ↓ ※144mg/dL以下を目標にすると、低血糖が増える ●測定方法 採血や血液ガスがベター 毛細管血を利用した簡易血糖測定は 測定誤差が大きく低血糖を見過ごすリスクあり
#110.
輸血考慮の基準 【RBC】 Hb7g/dL以下 or 活動性出血時 【FFP】 出血傾向 or 外科的処置時 + INR≧2.0 or APTT≧(正常値)×2 【PC】 Plt≦1万/μL or 出血傾向+ Plt≦5万/μL
PMX-DXPの有用性と推奨
#111.
敗血症におけるDIC診断 日本版敗血症診療ガイドライン2024 CQ5-1,2 DICと鑑別すべき疾患(TTP, HUS, HIT)は必ず除外 ➡抗凝固による有害事象のリスク↑ 線溶抑制型>>線溶亢進型 急性期DIC診断基準 日本救急医学会 早期診断できるが特異度△ overt-DIC診断基準 国際血栓止血学会 診断のタイミング遅くなるが より詳細に評価可能 煩雑 簡便
#112.
抗凝固による合併症との兼ね合いを考慮 ●DIC治療の原則は原疾患への治療介入 【敗血症DICに対する治療薬】 アンチトロンビン(CQ5-3):弱く推奨 トロンボモジュリン(CQ5-4):弱く推奨 タンパク分解酵素阻害薬(CQ15-6):行わないことを弱く推奨
#113.
期待されたビタミン療法… ビタミンC :1.5g 6時間ごと ×4日 ヒドロコルチゾン :50mg 6時間ごと ×7日 ビタミンB1 :200mg 12時間ごと ×4日 ●NFkB活性化の抑制 ●炎症性サイトカインのdown-regulation ●血管内皮のtight junctionを増加 ●ビタミンC→シュウ酸 (腎負荷)への代謝を抑制 C B
#114.
大量ビタミンC療法は行わないことを弱く推奨 ICU昇圧剤を要する敗血症患者 ビタミンC静脈投与群>プラセボ群 28日後の死亡 or 臓器不全のリスク Lamontagne F, et al. N Engl J Med. 2022 23;386(25) 敗血症における大量ビタミンC療法 日本版敗血症診療ガイドライン2024 CQ6-2
#115.
RRT(腎代替療法)の適応 日本版敗血症診療ガイドライン2024 CQ4-1
#116.
血液浄化方法を選択する上での 評価項目 循環動態不安定な敗血症性ショックの場合CRRTが多い
#117.
PMX-DXP
#118.
PMX-DXPの有用性を検証したstudy 第1弾 EUPHAS study (2009年) 第2弾 ABDO-MIX study (2015年) 第3弾 EUPHRATES study(2018年)
最新の敗血症診療ガイドラインの紹介
#119.
PMX-DXPの有用性を検証したstudy 第1弾 EUPHAS study (2009年) 第2弾 ABDO-MIX study (2015年) 第3弾 EUPHRATES study(2018年) 350,000円 どの試験でも、28日死亡率に有意差なし
#120.
世界でのPMXの推奨は…? 世界敗血症診療ガイドライン(SSCG2021) polymyxin Bを使用した血液浄化を 行わないことを提案 (Weak recommendation; low quality of evidence)
#121.
敗血症における急性血液浄化 日本版敗血症診療ガイドライン2024 CQ4-2~4 ●早期の腎代替療法は行わないことを弱く推奨 ●間欠的or持続的はどちらでもOK ▶循環動態が不安定な場合は持続的に ●血液浄化量は国際的な標準値(20-25ml/kg/hr) よりも増やさないことを強く推奨
#122.
発熱を伴う敗血症の解熱療法 日本版敗血症診療ガイドライン2024 CQ6-4 ●解熱療法(物理的、あるいは薬物的) ●死亡率やICU退室などの重要転帰は改善なし ●感染症合併症の発生率が増加する可能性は否定できない ●解熱のためのスタッフの仕事量増加やコスト増加 ●微生物に対する抵抗性が増す (=好中球・MΦ・NK細胞の活性化細菌増殖の抑制) ●患者本人の不快感 ●酸素消費の増大 →心肺機能へ負荷 ●ミトコンドリアなどの 細胞機能障害が生じうる 害 利
#123.
目次 ①ER編 1.敗血症の定義と診断基準 2.敗血症の診断・治療総論 3.敗血症治療のピットフォール ②ICU編 1.ショックの認識と生理学 2.治療の各論 ③敗血症×α おまけ編
#124.
便利なスマホアプリあります…! 「日本版敗血症診療ガイドライン2024 (J-SSCG2024)」アプリ版 iOS Android
#125.
ショートレクチャー視聴URL 百聞は一見に如かず… 敗血症の定義とガイドライン変遷 こちらをタップすると視聴できます👇 https://youtu.be/7xqjtW_ew44 敗血症の診断と治療総論 こちらをタップすると視聴できます👇 https://youtu.be/92P-4SVbq-M
#126.